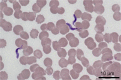
Figure 2.
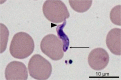
Figure 3.

Refractory hypoglycaemia in a dog infected with Trypanosoma congolense
- PMID: 26795063
- PMCID: PMC4722231
- DOI: 10.1051/parasite/2016001
Refractory hypoglycaemia in a dog infected with Trypanosoma congolense
Abstract
A 20 kg German shepherd dog was presented to a French veterinary teaching hospital for seizures and hyperthermia. The dog had returned 1 month previously from a six-month stay in Senegal and sub-Saharan Africa. Biochemistry and haematology showed severe hypoglycaemia (0.12 g/L), anaemia and thrombocytopenia. Despite administration of large amounts of glucose (30 mL of 30% glucose IV and 10 mL of 70% sucrose by gavage tube hourly), 26 consecutive blood glucose measurements were below 0.25 g/L (except one). Routine cytological examination of blood smears revealed numerous free extracytoplasmic protozoa consistent with Trypanosoma congolense. PCR confirmed a Trypanosoma congolense forest-type infection. Treatment consisted of six injections of pentamidine at 48-hour intervals. Trypanosomes had disappeared from the blood smears four days following the first injection. Clinical improvement was correlated with the normalization of laboratory values. The infection relapsed twice and the dog was treated again; clinical signs and parasites disappeared and the dog was considered cured; however, 6 years after this incident, serological examination by ELISA T. congolense was positive. The status of this dog (infected or non-infected) remains unclear. Hypoglycaemia was the most notable clinical feature in this case. It was spectacular in its severity and in its refractory nature; glucose administration seemed only to feed the trypanosomes, indicating that treatment of hypoglycaemia may in fact have been detrimental.
Un chien Berger allemand de 20 kg a été présenté à un hôpital universitaire vétérinaire français pour convulsions et hyperthermie. Le chien était revenu un mois auparavant d’un séjour de 6 mois au Sénégal et en Afrique sub-saharienne. La biochimie et l’hématologie ont montré une hypoglycémie sévère (0.12 g/L), une anémie et une thrombocytopénie. Malgré l’administration de grandes quantités de glucose (30 mL de glucose 30 % par voie IV et 10 mL de sirop de sucre à 70 % par une sonde naso-oesophagienne, chaque heure) 26 mesures consécutives de la glycémie (sauf une) étaient inférieures à 0,25 g/L. Un examen cytologique de routine de frottis sanguins a révélé de nombreux protozoaires extracytoplasmiques libres compatibles avec Trypanosoma congolense. La PCR a confirmé une infection par Trypanosoma congolense de type forêt. Le traitement a consisté en 6 injections de pentamidine à 48 heures d’intervalles. Les trypanosomes ont disparu des frottis sanguins 4 jours après la première injection. L’amélioration clinique a été corrélée à la normalisation des valeurs de laboratoire. L’infection a rechuté 2 fois et l’animal a reçu de nouveaux traitements ; les signes cliniques et les parasites ont disparu et le chien a été considéré comme guéri ; toutefois, six ans après cet incident, le test ELISA pour T. congolense était positif. Le statut de ce chien (infecté ou non infecté) demeure incertain. L’hypoglycémie était la caractéristique clinique la plus notable de ce cas. Elle était spectaculaire dans sa sévérité et dans son caractère réfractaire ; l’administration de glucose ne semblait que nourrir les trypanosomes laissant à penser que le traitement de l’hypoglycémie avait pu en fait être néfaste.
© J.-Y Deschamps et al., published by EDP Sciences, 2016.
Figures

References
-
- Akpa PO, Ezeokonkwo RC, Eze CA, Anene BM. 2008. Comparative efficacy assessment of pentamidine isethionate and diminazene aceturate in the chemotherapy of Trypanosoma brucei brucei infection in dogs. Veterinary Parasitology, 151(2–4), 139–149. - PubMed
-
- Anonymous. 1937. Hypoglycemic therapy in trypanosomiasis. Journal of the American Medical Association, 109(10), 795–796.
-
- Bengaly Z, Sidibe I, Ganaba R, Desquesnes M, Boly H, Sawadogo L. 2002. Comparative pathogenicity of three genetically distinct types of Trypanosoma congolense in cattle: clinical observations and haematological changes. Veterinary Parasitology, 108(1), 1–19. - PubMed
-
- Cornford EM, Freeman BJ, Payne KR, MacInnis AJ. 1975. Hyperglycemics, hypoglycemics and glucose metabolism in Trypanosoma lewisi. General Pharmacology, 6, 315–323.
-
- Davoust B, Herder S, Watrelot-Virieux D. 2006. Deux cas de trypanosomoses canines. Nouveau Praticien Vétérinaire, 143, 51–54.
Publication types
MeSH terms
Substances
LinkOut - more resources
Full Text Sources
Other Literature Sources
Medical
